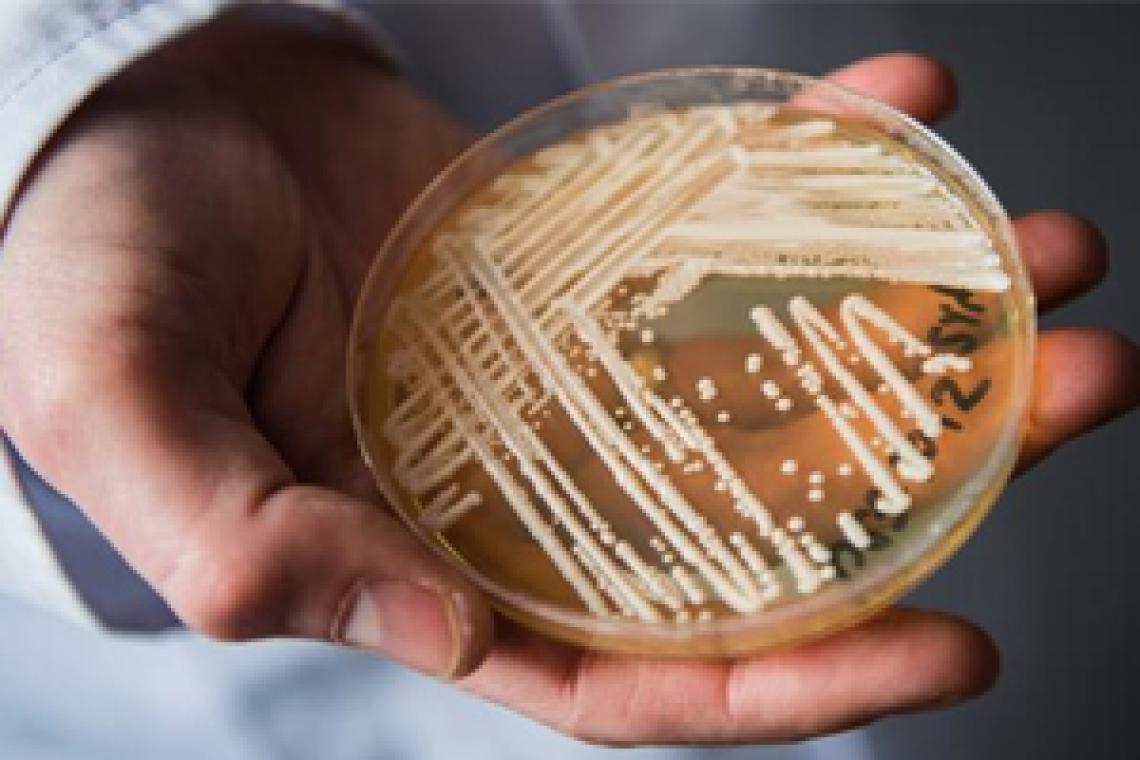
Brasil registra su primer posible caso de raro y potencialmente fatal hongo "Candida auris"

El "Candida auris", que según el Ministerio de Salud representa "una grave amenaza para la salud mundial", se identificó por primera vez en Japón en 2009.
Brasil detectó su primer posible caso de infección por el hongo Candida auris, un microorganismo superresistente a los principales fármacos conocidos y que es potencialmente mortal, informó este martes (08.12.2020) el Gobierno.
En un comunicado, la Agencia Nacional de Vigilancia Sanitaria (Anvisa, regulador), vinculada al Ministerio de Salud, explicó que fue notificada la víspera sobre el primer posible caso positivo del hongo, detectado en un paciente adulto que está ingresado en cuidados intensivos por complicaciones de COVID-19 en un hospital del estado de Bahía (nordeste).
Alerta a todos los servicios de salud
Tras conocer el caso, el regulador emitió una alerta a todos los servicios de salud y laboratorios de microbiología del territorio brasileño para que puedan adoptar las "acciones de prevención y control de la diseminación de ese hongo de forma oportuna y segura".
Asimismo, detalló que las autoridades sanitarias regionales y nacionales organizaron un grupo de trabajo conjunto para "acompañar el caso y prevenir la diseminación de C. auris en el país".
Ya se están llevando a cabo los análisis de los fenotipos para verificar el perfil de sensibilidad del microorganismo" y confirmar el diagnóstico, destacó Anvisa.
De acuerdo con el regulador, el Candida auris es un hongo emergente que representa una "grave amenaza a la salud global" y fue identificado por primera vez como causante de enfermedades en seres humanos en 2009, en Japón.
El patógeno puede propagarse con especial rapidez en ambientes sanitarios y entre pacientes hospitalarios.
Resistencia a fármacos antifúngicos
La Anvisa igualmente alertó de que las consecuencias dejadas por el hongo pueden ser potencialmente mortales, debido a que algunas cepas del C. auris "son resistentes a todas las tres principales clases de fármacos antifúngicos".
El hongo "puede causar una infección en la corriente sanguínea y otras infecciones invasoras, lo que puede ser mortal, principalmente en pacientes con comorbilidad", precisó.
Tras los "relatos de brotes de Candida auris en servicios de salud de América Latina", compilados por la Organización Pan-Americana de Salud en 2016, Anvisa elaboró un documento el año siguiente en el que detalló las orientaciones para la identificación, prevención y control del patógeno por parte de los laboratorios y centros de salud del país.
FEW (EFE, Reuters)